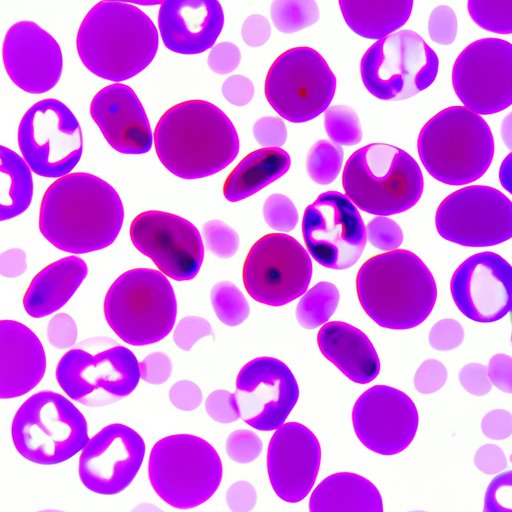

This comprehensive guide explores the process of becoming a surrogate, including eligibility requirements, legal and medical procedures, personal stories of surrogacy, and the pros and cons. Learn about health and wellness practices during pregnancy, financial considerations, frequently asked questions, and surrogacy laws. Discover how to become a surrogate and make a lasting impact on the lives of intended parents.
How to Reduce Inflammation in the Body Fast: Tips and Tricks
The article focuses on ways to reduce inflammation in the body fast. The article discusses dietary changes, physical therapies, mindfulness and relaxation techniques, anti-inflammatory supplements, and exercise as ways to reduce inflammation. The article provides tips for faster healing and good health and wellness.
Mastering Basic Time Conversions: How Many Minutes is 3 Hours?
This article explores how many minutes are in three hours and why it matters for our health and well-being. Learn simple formulas, shortcuts, and visual references for converting time units, and discover how the hours and minutes system evolved. Improve your time management skills and create a daily routine that promotes your health and productivity.
Why Do We Need Blood? Understanding the Biological, Medical, and Historical Significance of Blood
This article explores the purpose and function of blood, its role in medical treatments, its significance in history and culture, its connection to health and wellness, and the risks associated with infectious diseases. Understanding the importance of blood and donating blood when possible can help improve health outcomes for all.
Countdown to August 4th: Activities, Trivia, and Motivation
This article explores the significance of August 4th, including fun facts and historical events, and provides tips and suggestions on how to make the most of the remaining days. From health and fitness goals to summer activities and planning for upcoming celebrations, this article offers a variety of content to help readers stay motivated and achieve their goals.
How Many Steps Equal a Mile? Understanding the Mile-to-Step Ratio
Learn how to calculate how many steps are in a mile and understand the importance of the mile-to-step ratio for an effective workout routine. Discover how tracking your steps can benefit your overall health and wellness.
How Many Hours is 7am to 3pm: Maximizing Productivity and Staying Healthy in an Eight-Hour Workday
Find out how to make the most of the eight-hour workday and stay healthy while you’re at it. We discuss the history of the eight-hour workday, time management tips, health impacts of long work hours, and more.
Does GNC Sell CBD? A Comprehensive Guide for Buyers
Learn all about GNC and its role in the CBD market. This comprehensive guide provides buyers with tips, recommendations and safety considerations for navigating the complex world of CBD at GNC. Find out the best and worst CBD products available at GNC while educating yourself on CBD product labels and quality control measures.
The Story Behind Smilz CBD Gummies: Meet the Founders
Discover the inspiring story and journey of the founders behind Smilz CBD Gummies. Learn about their backgrounds, creative process, and vision for the future of CBD products.
Where Can I Buy CBD Oil in North Carolina? Your Ultimate Guide
Discover the top places to buy high-quality CBD oil in North Carolina and learn how to identify reliable suppliers in the growing CBD market. Get insights from interviews with CBD oil retailers and tips for choosing the right product for your health and wellness needs.